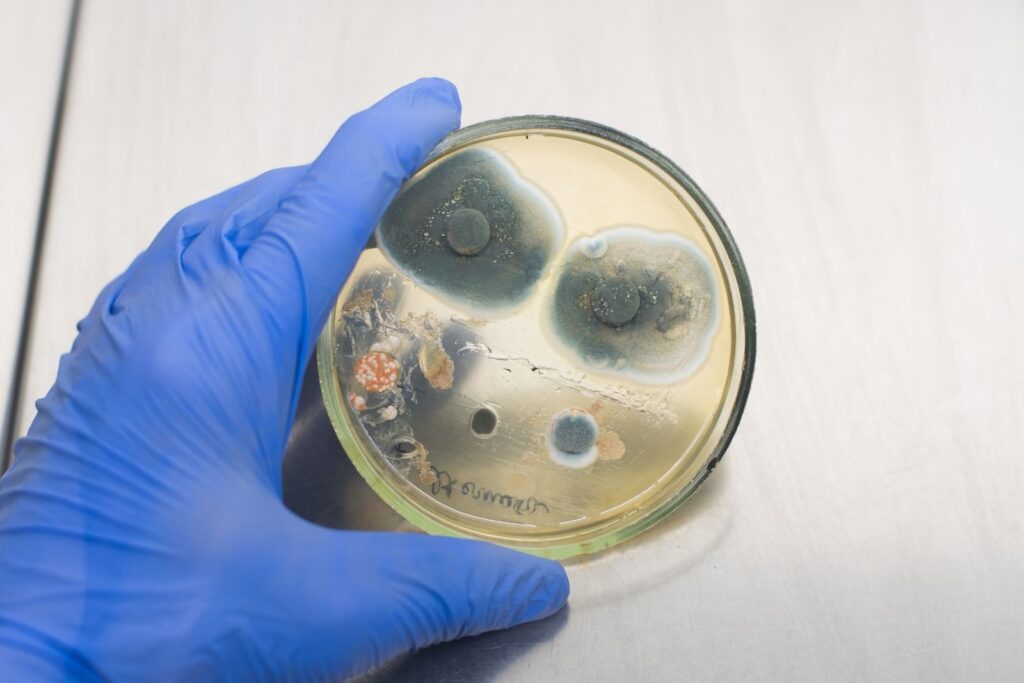

Haltbarkeit deiner Naturkosmetik – das solltest du wissen
Wie lange ist die Haltbarkeit deiner Naturkosmetik? Das ist eine sehr gute Frage und nicht in einem Satz beantwortet. In diesem Blogpost gehe ich dieser Frage deshalb für dich auf den Grund!

„Wie lange hält meine Kosmetik denn eigentlich?“ ist eine der am häufigsten gestellten Fragen, die mich erreicht.
Dass diese Frage ziemliche Unsicherheit und Unwissenheit hervorruft, zeigen auch die Antworten und Tipps in zahlreichen Facebook-Gruppen, die zum Beispiel Vitamin E als Konservierungsmittel anpreisen oder in der „geschimpft“ wird, wenn man rein ölhaltige Kosmetik nicht konserviert. (Was übrigens auch nicht nötig ist, mehr dazu später).
Aus diesem Grund habe ich mich entschieden die wichtigsten Fakten (Ja! Es gibt noch viel mehr über die Haltbarkeit deiner Naturkosmetik und die Konservierung zu sagen) in diesem Blogpost zusammenzufassen und so hoffentlich zu etwas Klarheit beitragen zu können! 🙂
Fakt 1 – Richte dich immer nach dem am kürzesten haltbaren Rohstoff
Grundsätzlich kannst du die Haltbarkeit deiner Naturkosmetik am kürzesten haltbaren Rohstoff ausmachen. Dieser bestimmt quasi die Haltbarkeit in erster Linie.
Während du bei einem Balsam, bestehend aus Wachs und Öl, das Öl für die Bestimmung der Haltbarkeit heranziehst, ist dies bei einer Emulsion die Wasserphase.
Und dass ein Öl wesentlich länger haltbar ist als ein Hydrolat, das ist logisch. Wikipedia schreibt zum Beispiel sehr schön „Ein Hydrolat ist ein Produkt, das nicht stabil ist und sehr schnell verkeimt“.

Und genauso ist es auch: Sonnenblumenöl hat zum Beispiel eine Haltbarkeit von ca. 9 Monaten nach Öffnung. Hydrolate sollten nach Öffnung innerhalb weniger Wochen aufgebraucht werden.
Und diese Angabe stimmt auch nur dann, wenn du das Hydrolat direkt aus dem vom Produzenten steril abgefüllten Fläschchen verwendest, ohne es Sauerstoff oder Quellen der Verunreinigung auszusetzen.
In dem Moment, in dem du das Fläschchen öffnest um einen Teil des Hydrolats für deine Kosmetik zu umzuleeren, ist die ursprüngliche Haltbarkeit bereits hinfällig.
Darum ist es so wichtig, deine Kosmetik bei der Verwendung einer Wasserphase zu konservieren und ausschließlich mit frischen Rohstoffen zu arbeiten – egal ob du eine rein ölhaltige Zubereitung oder eine Emulsion machst.
Nur mit frischen Rohstoffen erreichst du das Maximum an Haltbarkeit deiner Kosmetik!
Verwendest du nämlich Rohstoffe, die bereits das Ende ihrer Haltbarkeit erreichen wird auch die Haltbarkeit deines Kosmetikprodukts damit verkürzt. Ein Rohstoff, der bereits kurz vorm Ablauf ist, wird nicht besser oder länger haltbar, wenn du ihn in deiner Kosmetik einsetzt.
Merke:
- Der am kürzesten haltbare Rohstoff bestimmt die Haltbarkeit deiner Kosmetik grundsätzlich
- Verwende immer nur frische Rohstoffe, um das Maximum an Haltbarkeit deiner Kosmetik zu erreichen
Fakt 2 – ölhaltige Kosmetik wird nicht konserviert und Vitamin E ist kein Konservierungsmittel
Rein ölhaltige Kosmetik wie zum Beispiel ein Gesichts- und Körperöl oder einen Balsam musst du nicht konservieren. Dies trifft eben nur auf Produkte mit Wasserphase zu.
Was du jedoch machen solltest, um die Haltbarkeit deiner rein ölhaltigen Kosmetik zu verlängern ist, dass du sogenannte Antioxitantien wie zum Beispiel Vitamin E (INCI: Tocopherol) zugibst.

Vitamin E sorgt dafür, dass der Oxidationsprozess des Öls verlangsamt wird, sprich dass es nicht so schnell ranzig wird. Außerdem wirkt es hautpflegend.
Finden hingegen Oxidationsprozesse statt, so entstehen unangenehm riechende und hautreizende Oxidations- und Spaltprodukte, die das Produkt unbrauchbar machen.
Merke:
- Rein ölhaltige Produkte werden nicht konserviert, stattdessen wird ihre Haltbarkeit durch die Zugabe von Antioxidantien verlängert
Fakt 3 – Davor wollen wir unsere Kosmetik schützen
Dass bestimmte Mikroorganismen zu einer gesundheitlichen Beeinträchtigung
des Menschen führen können ist bekannt. Daher müssen auch Mikroorganismen in Kosmetikprodukten als potentielles Gesundheitsrisiko angesehen werden.
Mikroorganismen, die die Haltbarkeit in unserer Naturkosmetik beeinträchtigen:
- Bakterien
- Schimmelpilze
- Hefepilze
Bakterien benötigen Feuchtigkeit, Nährstoffe, Wärme, Zeit und in den meisten Fällen Sauerstoff, um sich vermehren zu können. Bakterien können sich alle 20 Minuten vervielfachen.
Schimmelpilze benötigen Wasser, Sauerstoff und Nährstoffe um sich vermehren zu können. Bei Zimmertemperatur ernähren sich die Schimmelpilze von der Kosmetik und multiplizieren sich super schnell.
Hefepilze sind als Problem in der Nahrungsmittelindustrie weit verbreitet und die gleiche Problematik gilt auch für Naturkosmetik. Hefepilze benötigen Wasser, Nährstoffe und die Abwesenheit von Sauerstoff, wobei sich manche auch trotz Sauerstoff vermehren können.
Speziell Hefepilze begegnen uns bei Ölmazeraten, bei denen wir frisches Pflanzenmaterial ausgezogen haben und zwar über mehrere Wochen. Die frischen Pflanzen sind wasserreich und das Öl sorgt dafür, dass kein Sauerstoff zum Pflanzenmaterial kommt – ein Fest für die Hefepilze.
Ich bevorzuge daher als Auszugsmethode den Warmauszug, bei dem das Risiko minimiert werden kann.
Mikroorganismen heißen sie übrigens nicht ohne Grund: Bakterien, Schimmel- und Hefepilze sind so klein, dass wir sie mit freiem Auge nicht sehen können. Auch ihre Auswirkungen in unserem Kosmetikprodukt erkennen wir mit freiem Auge erst dann, wenn die Verkeimung bereits weit fortgeschritten ist.
Fakt ist: eine Emulsion kann bereits eine für unsere Haut kritische Verkeimung aufweisen, ohne dass wir es ihr ansehen oder es am Geruch feststellen.
Heike käser
Unkonservierte, wasserhaltige, in Cremetiegel abgefüllte Zubereitungen, sind nach dem Öffnen maximal zwei Wochen bei Lagerung im Kühlschrank bei der Entnahme mit einem Spatel haltbar.(1)
Die Mikroorganismen selbst können eine erhöhte Infektionsgefahr darstellen, doch was manchmal vergessen wird ist, dass viele Mikroorganismen auch hochgiftige Stoffe produzieren, die hautreizend und zelltoxisch wirken(2) – ein Beispiel sind die von bestimmten Schimmelpilzen produzierte krebserregende Aflatoxinen.(3)
Haltbarkeit deiner Naturkosmetik überschritten? Symptome eines verkeimten Produkts
Verunreinigungen können sich neben dem optischen Faktoren wie Schimmel, Schaum- oder „Wölkchenbildung“ auch durch eine Trennung der Phasen nach mehreren Tagen, Farb- oder Geruchsänderungen bemerkbar machen.
Irrglaube: Die Verunreinigung entsteht erst nach einiger Zeit
Ein weiterer Irrglaube ist, dass die Verunreinigung oder Verkeimung erst nach einiger Zeit entsteht.
Fakt ist jedoch, dass sogar Rohstoffe bereits von Mikroorganismen befallen sein können. Gerade natürlich gewonnene Rohstoffe sind naturgemäß mit Mikroorganismen besiedelt.
Dies macht eine ordentliche Handhabe mit dem Thema Konservierung gerade bei der Naturkosmetik besonders wichtig und wir müssen eventuell vorhandene Bakterien und Pilze daran hemmen sich weiter zu vermehren und die Grundkontamination so gering wie möglich zu halten.
Von einigen Rohstoffshops weiß ich, dass diese ihre Rohstoffe im Labor auf Verunreinigungen untersuchen lassen um sicherzugehen, dass diese frei von Mikroorganismen und Keimen sind. 🙂
Merke:
- Verunreinigungen siehst du mit freiem Auge erst, wenn sie bereits kritisch vorangeschritten ist!
- Die Verursacher sind Bakterien, Schimmel- oder Helfepilze
- Auch Rohstoffe können diese Verunreinigungen bereits mitbringen
- Mehr zum Thema Verkeimung und Konservierung findest du natürlich auch bei Heike Käser: Naturkosmetik konservieren | Basiswissen
Fakt 4 – So erreichst du die längste Haltbarkeit deiner Naturkosmetik
Nachdem wir nun geklärt haben, wovor wir unsere Kosmetik „schützen“ möchten und dass eine Grundverunreinigung bereits durch Rohstoffe entstehen kann, gibt es noch einen weiteren Punkt, der wichtig ist für die Haltbarkeit unserer Kosmetikprodukte.
Kosmetikprodukte müssen – anders als Arzneimittel – nicht steril sein. Und sie können es bei uns zu Hause auch niemals sein, so sauber wir auch arbeiten.
Aus diesem Grund ist es besonders wichtig, dass wir folgende Punkte beachten:
- Good Manufacturing Practice, bei mir liebevoll „sauber und hygienisch Arbeiten“ genannt. Hier findest du meine Anleitung dazu.
- Verlängere die Haltbarkeit deines Kosmetikprodukts. Verwende bei rein ölhaltigen Produkten immer ein Antioxidanz wie Vitamin E und achte auf eine ausreichende Konservierung bei wasserhaltigen Kosmetikprodukten.
- Achte auf eine gute Verpackung – lichtgeschützt, am besten Airlesspender oder Pumpspender.

So konservierst du deine Naturkosmetik
Möchtest du deine Naturkosmetik konservieren, kannst du auf verschiedene Methoden zurückgreifen.
Du kannst immer Kleinstgebinde produzieren, diese innerhalb von 1-2 Wochen im Kühlschrank gelagert aufbrauchen und nur mit Spatel entnehmen.
Entschließt du dich für eine Konservierung, hast du die Auswahl zwischen Alkohol und Konservierungsmitteln.
Der Vorteil von Alkohol ist, dass du auch weitere Wirkstoffe aus Pflanzen zuführen kannst, wenn du statt zu reinem Alkohol zu Tinkturen greifst.
Alkohol wirkt sehr gut bei Bakterien und gut bei Hefen und Schimmel.(4)
Bei manchen Kosmetikprodukten (speziell um die Augen) möchte ich jedoch nicht zu Alkohol greifen. Hier kannst du wunderbar auf mittlerweile sehr gut verträgliche Konservierungsmittel zurückgreifen.
Es gibt gute Breitbandkonservierungsmittel wie zum Beispiel Rokonsal, das ebenfalls sehr gut bei Bakterien wirkt und gut bei Hefen und Schimmel. Auch Geogard 221 fällt in diese Sparte. (4)
Trägt auch zur Haltbarkeit deiner Naturkosmetik bei: So verpackst du deine Kosmetik ideal
Last but not least kommen wir auf das Thema Verpackung, denn nur wenn du dein Kosmetikprodukt auch ordnungsgemäß aufbewahrst, wirst du lange Freude daran haben.
Idealerweise nimmst du ein lichtgeschütztes Tiegelchen oder noch besser einen Pump- oder Airlesspender.
Lichtgeschützt ist zum Beispiel Braun-, Bunt- oder speziell Violettglas oder natürlich auch nicht-transparenter Kunststoff.
Verwendest du zusätzlich zum Lichtschutz kein offenes Tiegelchen, sondern einen einen Pump- oder Airlessspender minimierst du den Sauerstoff, der an dein Kosmetikprodukt kommt. Außerdem verhinderst du so, dass du dein Produkt durch Hineingreifen mit den Fingern zusätzlich verkeimst.
Denn wie wir wissen, tummeln sich ja auch auf unserer Haut zahlreiche Mikroorganismen! 😉

Und du?
Wusstest du bereits alles über die Haltbarkeit deiner Naturkosmetik, das ich dir heute zusammengefasst habe? Was ist dir neu?
Und an alle Profis: Natürlich gibt es noch viel mehr zum Thema Haltbarkeit deiner Naturkosmetik und Konservierung zu sagen, aber es soll einfach einmal ein grober Überblick sein für alle, die sich mit diesem Thema erst auseinandersetzen möchten. 🙂
Hinterlass mir super gerne einen Kommentar!
Alles Liebe,
Julia
Quelle:
(1) Ellsässer Sabine: Körperpflegekunde und Kosmetik. Berlin: Springer Verlag. 2020, 3. aktualisierte Auflage, S. 54
(2) https://www.olionatura.de/basiswissen/naturkosmetik-konservieren
(3) Heymann Eberhard, Prof. Dr.: Haut, Haar und Kosmetik. Bern: Verlag Hans Huber. 2003, 2. Auflage, S. 166
(4) Käser Heike: Naturkosmetik selbermachen. Linz: Freya Verlag. 2016, 5. aktualisierte Auflage, S. 138
Bitte beachte: Die von mir zur Verfügung gestellten Informationen werden mit aller Sorgfalt zusammen getragen. Die Rezepte sind ausschließlich auf gesunder, intakter Haut anzuwenden und die Anwendung der Rezepte erfolgt auf eigene Verantwortung und Gefahr. Die vorgestellten Inhalte in Bezug auf Hautpflege, Hausmittel, ätherische Öle oder Heilkräuter ersetzen keinen Besuch beim Arzt! Bei Schwangeren und Kindern sowie bei Vorerkrankungen vorab eine Anwendung oder Einnahme mit dem Arzt abklären.
In keinem Fall hafte ich oder mit mir verbundene Gesellschaften oder deren Inhaber/Angestellte für Personen-, Sach- und Vermögensschäden oder Verluste irgendwelcher Art. Eingeschlossen sind direkte, indirekte oder Folgeschäden.

Herzlichen Dank für diese wunderbare kurze Zusammenfassung. Ich bin bisher wohl viel zu sorglos mit den verschiedenen Produkten umgegangen. Spezielle die Hinweise auf eine mögliche Verkeimung von Rohstoffen fand ich sehr interessant – für mich auch ganz neu.
Ich werde sehr gerne wieder bei dir vorbeischauen.
Guten Morgen liebe Ingrid,
ich freue mich sehr, dass dir die Zusammenfassung hilft. Und ja, das ist ein voll spannendes Thema, das es meiner Meinung nach viel zu selten aktiv besprochen wird – gerade weil es so relevant ist.
Ganz liebe Grüße,
Julia
Vielen Dank für diese zusammen gefassten Informationen.
VG Petra
Sehr gerne liebe Petra! 💗
hey, seid 25 jahren beschäftige ich mich mit diy-kosmetik. angefangen durch die psoriasis meines ersten sohnes. ein großes kompliment! selten eine so kurz und bündig und gleichzeitig faktisch das notwendigste zusammengefasst zu diesem thema hab ich bislang so noch nicht gefunden!
danke für die mühe, ich schaue hier wohl in zukunft gerne öfter rein
weiterhin viel freude mit der materie, ima
Hallo Ima,
wow, vielen lieben Dank für deinen Kommentar – ich freue mich rieeeeeeeeeesig!! 💗💗💗💗
Gaaaaaaaaaaanz liebe Grüße,
Julia
An den meisten Konservierungsstoffen stören mich einzelne Zutaten (Fettalkole, da komedogen, Sorbate, da mir unverträglich, duftende (Geogard 221) und/oder Duft maskierende Zutaten (Biokons Neo) bei Kosmetika mit ätherischen Ölen …), eine kompliziertere Verarbeitung, die Notwendigkeit, mehrere einzelne Stoffe zu kombinieren (zB Magnolienextrakt, Dermosoft GMCY & Propylenglycol) und/oder für nur wenig Rührende zu große Gebinde, sodass man einen ganzen Teil entsorgen müsste.
Ich hab dann eine Weile lang Biokons Neo verwendet, der Rosenduft war toll & nervig zugleich, wenn er einem aus jedem Produkt entgegenschlägt & man Duft lieber über Naturparfum haben mag. 😉 Wunderbar, wenn man intensive Düfte kaschieren möchte oder solche, deren Wirkung, nicht aber Duft erwünscht ist. Irgendein ätherisches Öl, das mir zu drüber war & Biokons Neo hoben sich vor einiger Zeit mal fast auf, da wars ok. 😉
Im letzten Herbst hab ich dann ein Breitband-Konservierungsmittel in Pulverform entdeckt, in DE aktuell nur bei Dragonspice erhältlich – Sodium LAAS. Es enthält die gleichen konservierenden Stoffe (Sodium Anisate & Sodium Levulinate) wie Dermosoft 1388 eco, aber eben nur die, ohne Wasser & Glycerin. Feinst dosierbar, ergiebig (1%), kein Eigengeruch, lange Haltbarkeit spendend (natürlich unter Heimrührbedingungen nicht die angegebenen 8 Monate!), kompakt, keine besonderen Lagerbedingungen, in kleinen Mengen erhältlich, erschwinglich & da ohne Wasser länger haltbar. Ich mags so puristisch! 🙂
Meine ersten 10g davon habe ich aufgebraucht, in 50g-Portionen gerührte Muskelcreme, Deocreme etc, die ich im Badschrank aufbewahre & mit gewaschenen Händen entnehme, hält ohne sicht- und riechbare Veränderungen, bis leer – es sei denn, ich hab wieder zu viel mit Emulgatoren experimentiert & es trennt sich was, aber das ist ein anderes Thema. 😉
Hallo Anke,
danke für deinen Einblick, wie toll, dass du den richtigen Konservierer für dich gefunden hast!
Und puristisch ist immer toll, da bin ich bei dir 🙂
Alles Liebe,
Julia
Tolle Übersicht Jules!
Ich hab letztens mal gelesen dass man auch Glyzetin verwenden kann. Allerdings habe ich das nirgends bestätigen können. Was meinst du dazu?
Danke und liebe Grüße,
Viktoria
Hallo Viktoria,
meinst du Glyzetin als Rohstoff? Das kenne ich gar nicht und hab auf eine kurze Recherche hin auch nichts gefunden. Kannst du mir da einen Link oder ähnliches schicken?
Alles Liebe,
Julia
Hallo Julia! Du schreibst, dass du gerne Airelss Spender nimmst für deine Kosmetik – was mir daran nicht gefällt ist, dass man diesen dann wegwerfen muss – einen Tiegel kann man gut reinigen und desinfizierten und daher öfter verwenden – oder seh ich das falsch?
Hallo liebe Helga,
mit der Reinigung hast du natürlich recht, da ist ein einfaches Tiegelchen leichter zu reinigen.
Es kommt halt immer darauf an, was du einfüllst. Ein Balsam zum Beispiel ist weit weniger anfällig, als ein Serum.
Ich überlege daher immer, wie anfällig mein Produkt ist und entscheide mich dann, in welchen Behälter ich es abfülle.
Fülle ich eine Creme in ein Tiegelchen, dann entnehme ich es ausschließlich mit einem Spatel, da sonst die Verkeimung begünstigt wird. Da ist ein Pumpspender eben viel besser geeignet.
Im Endeffekt bleibt es immer deine persönliche Vorliebe und deine Entscheidung!
Alles Liebe,
Julia
Man kann wieder befüllbare „airless“-Flacons kaufen. Z.B. bei AromaZone. Sehr gut gemacht/durchgedacht. Ich bin sehr zufrieden. Man kann sie vor allem wieder ohne Angst zu abwürgen öffnen. Ich musste mir bei denen nur abgewöhnen wie Gläser mit kochendem Wasser überbrühen, denn nicht alle Plastikarten halten es ohne Deformation aus. Nachdem Auswaschen und Trocken reicht nur Alkohol kurz vor dem Produkteinfüllen
https://www.aroma-zone.com/info/fiche-technique/flacon-airless-trendy-100-ml-aroma-zone.
Danke für den Tipp, die kannte ich noch gar nicht! 🙂
Alles Liebe,
Julia
Danke für die gute Übersicht, liebe Julia!
Sehr sehr gerne liebe Nici!
Alles Liebe,
Julia